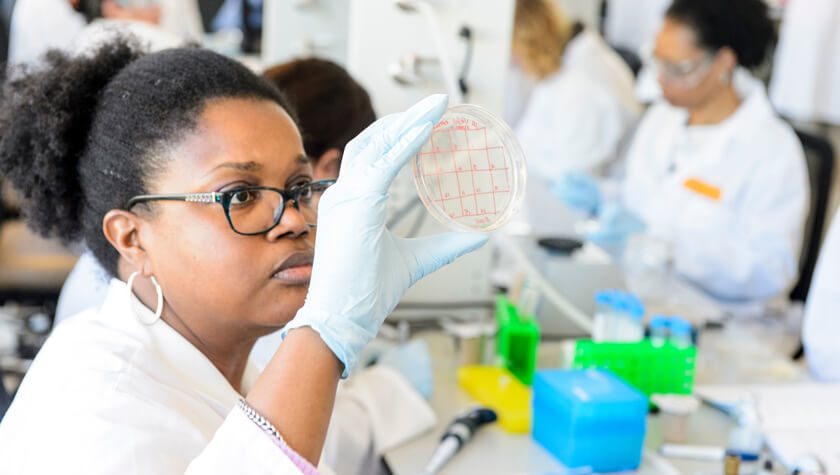

Our Master of Science in Pharmaceutical Sciences: Applied Drug Development prepares you for a variety of roles within the pharmaceutical and biotech industries. In particular, you’ll gain the skills required to work in a regulated environment as well as drug action, statistical, and data analysis skills. The combination of technical knowledge and relevant soft skills (critical thinking, problem solving, interpersonal skills, communication skills, etc.) from this program will put you at the top of applicant pool.
Recent job titles for careers in pharmaceutical sciences include:
- Research Associate
- Research Technician
- Researcher
- Technician
- Scientist
- Process Technician
- Quality Assurance Associate
- Regulatory Affairs Specialist